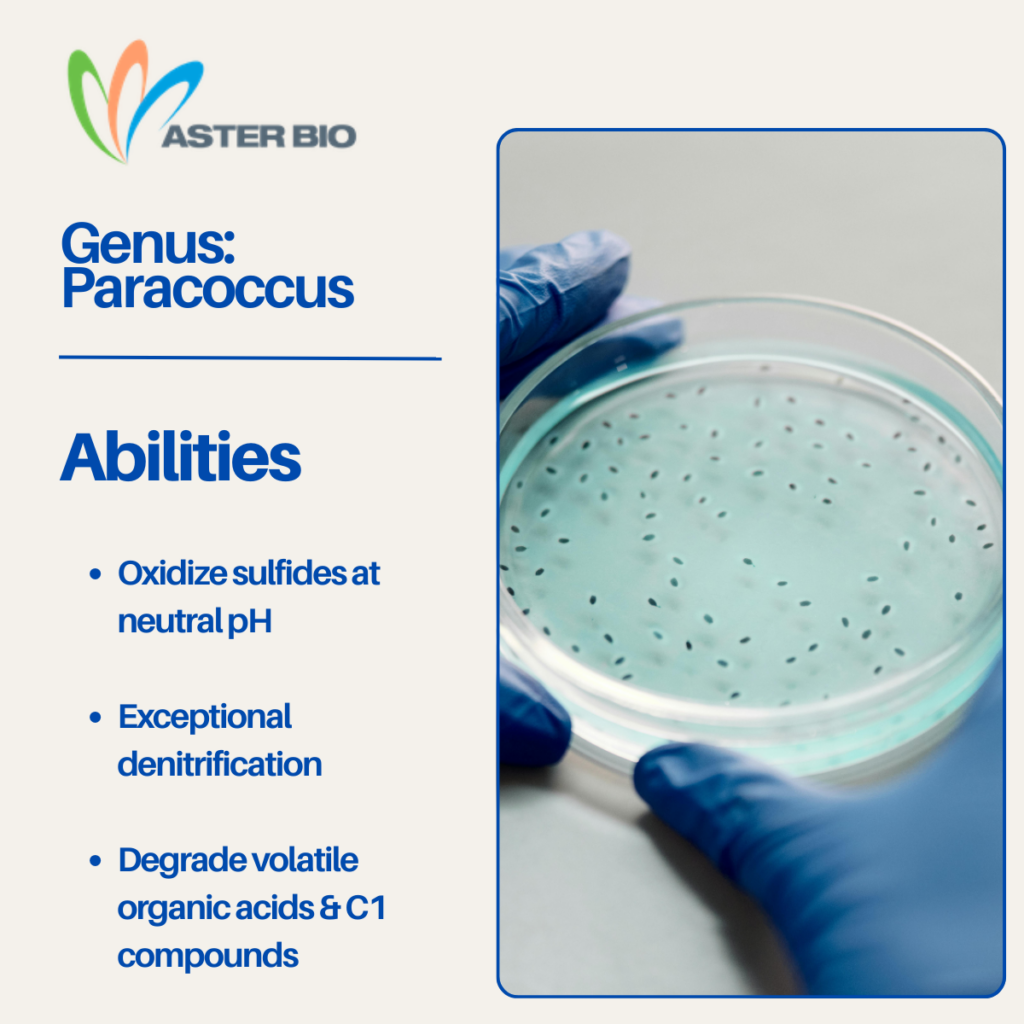

Wastewater treatment professionals are increasingly leveraging microbial community analysis to optimize plant performance. Among the diverse microbial genera present, Paracoccus stands out for its multifaceted contributions to nitrogen and sulfur cycling, as well as odor mitigation. The most prominent species in wastewater applications are Paracoccus denitrificans, Paracoccus pantotrophus, and Paracoccus versutus.
Sulfide Removal at Neutral pH
Hydrogen sulfide (H₂S) is a toxic, corrosive, and odorous compound commonly encountered in biogas and wastewater streams. Paracoccus versutus CM1 has been shown to efficiently oxidize H₂S under neutral pH conditions, both in laboratory and pilot-scale biofilters. Immobilized Paracoccus biofilters achieved >99% H₂S removal, with high elimination capacities and no reduction in methane content, making them ideal for biogas purification and odor control. PCR-DGGE analysis confirmed Paracoccus as a dominant genus in these systems, highlighting its robustness and adaptability.
Efficient Denitrification
Paracoccus denitrificans and Paracoccus pantotrophus are recognized for their ability to perform complete denitrification, converting nitrate (NO₃⁻) all the way to nitrogen gas (N₂). This is crucial for preventing eutrophication and meeting stringent nitrogen discharge limits. These bacteria are facultative anaerobes, capable of denitrification under both aerobic and anaerobic conditions. Recent studies demonstrate that Paracoccus denitrificans R-1 can simultaneously assimilate ammonium and reduce nitrate, with high removal rates under both oxygen-rich and oxygen-poor environments. Genomic analysis confirms the presence of genes for both ammonium assimilation and denitrification, enabling efficient nitrogen removal in a single reactor.
Moreover, Paracoccus species are heterotrophic denitrifiers, utilizing organic molecules—including pollutants—as carbon sources. This trait allows them to degrade nitrogenous compounds in anaerobic environments, extending their utility to a wide range of bioremediation processes.
Degradation of Odor-Causing Volatile Organic Acids
Odor control is a persistent challenge in wastewater treatment, especially in municipal, food processing, and petrochemical plants. Paracoccus species are uniquely equipped to grow on short-chain volatile fatty acids (VFAs) and C1 compounds, which are often inhibitory to other microorganisms. Their metabolic versatility enables them to degrade these odor-causing compounds, thereby protecting vital nitrifying bacteria and improving overall plant stability.
Practical Applications and Bioaugmentation
The versatility and efficiency of Paracoccus spp. have led to their inclusion in bioaugmentation strategies. By introducing targeted Paracoccus cultures, operators can enhance denitrification, sulfide oxidation, and odor mitigation, especially in systems challenged by inhibitory substrates or fluctuating influent characteristics.
Summary
Paracoccus spp. are invaluable assets in modern wastewater treatment plants. Their ability to efficiently remove sulfide at neutral pH, perform complete denitrification, and degrade volatile organic acids positions them as key players in maintaining environmental compliance and operational stability. For technical professionals, integrating Paracoccus into microbial management strategies offers a pathway to improved treatment outcomes and sustainable plant operations.
References:
- Paracoccus: Important organisms for denitrification and sulfide oxidation in wastewater treatment systems
- Removal of Hydrogen Sulfide from Swine-Waste Biogas on a Pilot Scale Using Immobilized Paracoccus versutus CM1
- Efficient nitrogen removal via simultaneous ammonium assimilation and heterotrophic denitrification of Paracoccus denitrificans R-1
- Heterotrophic Denitrification and Paracoccus spp. as Tools for Bioremediation